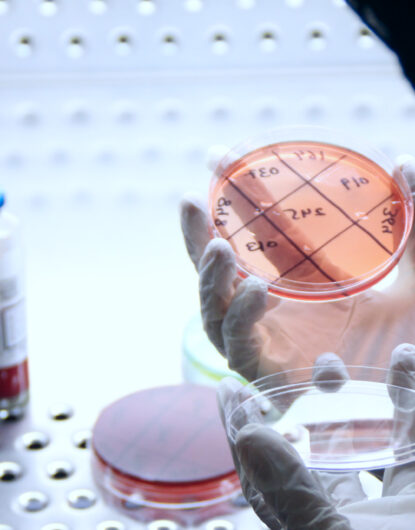

Excellence. Integrity. Care.
The Foremost Diagnostic
Authority in Pakistan
Your health warrants nothing less than the finest. Utilizing
state-of-the-art technology, leading medical experts…
Find Your Doctor
Expert Healthcare Consultation
Find Recommended Diagnostics Investigation
CDC Newsletters
Our Locations
About Us
Why Choose Capital Diagnostic Centre?
Medical Treatment
Advanced Diagnostics
Consecte
Immunology
Equipment
Medicine
Scientific
Research
Precision. Care. Trust. Your Health, Our Priority!
Comprehensive Healthcare
& Diagnostic Services
Electroencephalography (EEG)
Electromyography (EMG)
Nerve Conduction Study (NCS)
Spirometry
Home Diagnostic Services
Malaysia Approved Medical Center
Organizational Medical Panel
CDC Pharmacies
Endoscopy
MRI
Multi-Slice CT Scan
DR‑CR X‑Ray
Interventional Radiology
Dental Radiography
Ultrasound
DEXA Scan
Clinical Chemistry
Hematology
Histopathology
Immunology
Clinical Pathology
Microbiology
Molecular Biology
Parasitology
Special Chemistry
Echocardiography (Echo)
Electrocardiogram (ECG)
Exercise Tolerance Test (ETT)
Holter Monitoring Test
Our promises
Why Choose CDC?
Because Your Health Matters!
- Home Diagnostic Services
- Covid 19
- Competitive Prices
- 24/7 Support
- Huge Branch Network
Home Diagnostic Services - At Your Door Step
Convenient, Reliable, and Accurate Lab Testing at HomeLooking for a trusted medical laboratory? At Capital Diagnostic Centre (CDC), we bring high-quality diagnostic services to your home with our Home Sample Collection. Get your lab tests done easily, safely, and accurately — without stepping out!
- No more waiting in long queues—book your test from home.
- State-of-the-art labs ensure precise and reliable results.
- Trained professionals follow strict hygiene protocols.
- Get your reports delivered digitally and on time.
COVID-19 Test & Vaccination – Protecting You & Your Loved Ones
"Your First Line of Defense Starts with Trusted Diagnostics." At Capital Diagnostic Centre (CDC), we offer accurate, fast, and government-approved COVID-19 testing and vaccination services. Whether you’re preparing for travel, experiencing symptoms, or simply taking preventive steps, CDC ensures you get the care you need with precision and professionalism.- MOH-Approved & IATA-Recognized Reports
- Travel & Corporate Clearance Friendly
- Home Sampling & Blood Collection Available
- Affordable Individual & Family Packages
Competitive Prices – Affordable Healthcare for Everyone
At CDC, we believe that top-notch medical services should be affordable for all. Our competitive pricing ensures that you get high-quality diagnostics, treatments, and healthcare solutions without financial stress. Whether it’s routine check-ups, lab tests, or specialized procedures, we offer cost-effective rates without compromising on accuracy, efficiency, or patient care.- Top-tier medical services at budget-friendly rates.
- Customized medical plans to suit every budget.
- Clear and upfront costs with no surprises.
- Get advanced diagnostics and expert care at affordable rates.
24/7 Support – We're Always Here for You!
At CDC, your health is our priority! Our 24/7 support team is available round the clock to assist you with appointments, medical inquiries, and emergency guidance. Whether it's day or night, we're here to ensure you receive the care and information you need—when you need it most!- Get expert assistance anytime, 24/7.
- Quick and reliable medical guidance at your fingertips.
- Connect with professionals for urgent medical support.
- Book tests and consultations hassle-free, anytime.
Huge Branch Network – Accessible Healthcare Everywhere!
At CDC, we are committed to making healthcare accessible with our wide branch network across the region. No matter where you are, you can find a CDC branch near you, offering advanced diagnostics, expert consultations, and reliable medical services for your convenience.- Easily accessible branches across various cities.
- Same high-quality medical services at every location.
- Find a branch near you for quick and efficient care.
- State-of-the-art medical technology at every branch.
250 +
Professional and Experiencedstaff ready to help you
14 m
Solution minimize the cost andincrease the velocity
430 +
Tests Completed Rapidly , Complier ,Accurate and Precisely.
30 k
Professional Client Satisfaction RateFor Services
Client Reviews
Trusted by thousand of
people & companies.
“I recently visited the Capital Diagnostic Center’s G8 main branch and was thoroughly impressed with the exceptional service and care I received. The facility was modern, spacious, and spotlessly clean. The staff were highly professional, friendly, and attentive.”
Muhammad Zeeshan

“Located at newly built building, Crescent Arcade G-8 Markaz. Parking is available with wheel chair accessibility. They got other old branch situated at Media foundation building near the play ground at G-8 Markaz. New place is clean and spacious, staff is helpful further improvements are needed.”
sSs Ali

“Dr. Jai Krishan is the best paediatric in Islamabad. Very experienced doctor and humble person. Walk in patients had to wait a while so it’s better to book your appointment in advance as there are always too many patients at the hospital.”
AJ

“Dr. Jai Krishin is very good doctor. But its appointment is very difficult. Needs to improve the procedure for onlinel appointments. Overall good experience.”
Nauman Khan

“Great place with great services. The owner himself takes Interest personally to make sure things are managed in the best way. I would also recommend for all types of diagnosis and treatment. The neurologist there was also good!”
Saif Ur Rehman

“It’s established and organized Diagnostic Centre situated at Media Foundation Building G-8 Markaz Islamabad. Our Mission is underlying causes of illness. We are committed to Improving health through high quality diagnostics, research and Health education. It gives us great pleasure to introduce Capital Diagnostic Centre which provides wide range of diagnostic Facilities under one roof:”
Ahmad Khan

Al Falah Insurance

Shahzad Oil Traders

National Press Club

Tehzeeb Backers

Allama Iqbal Open University

FIA

Shafi Medical Rehabilitation Complex

Tandoori Restaurant

Laboratory Services
Advanced Diagnostics for
Accurate & Reliable Results

Nanostructured Materials


CDC Blog
Stay Informed,
Stay Healthy!